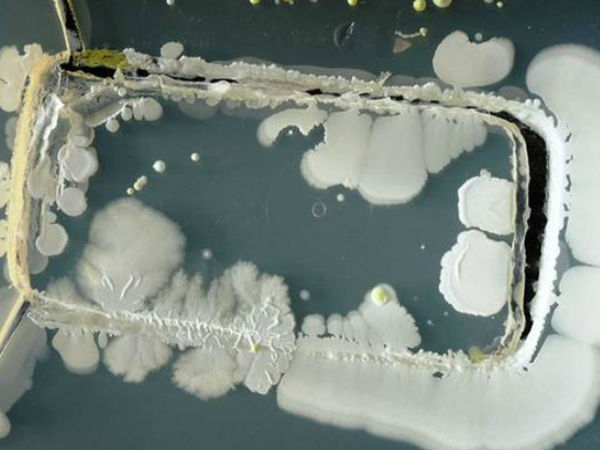
09. தொற்று :

அதிர்ச்சி : மலட்டுத் தன்மையை உண்டாக்கும் மொபைல் போன்கள்..!
நம் கையில் 5 நிமிடங்கள் மொபைல் போன் இல்லாத போது தான் தெரியும் - நாம் மொபைல் போன்களுக்கு எந்த அளவு அடிமையாக உள்ளோம் என்பது. இருப்பினும், மொபைல் போன்கள் மிகவும் அத்தியாவசியமாகி விட்டது என்று நாம் நினைத்து சுய சமாதானமாகிக் கொள்கிறோம்..!
உண்மை தான், தற்காலத்தில் மொபைல் போன் இல்லை என்றால் ஒரு கை இல்லாதற்க்கு சமம் தான். இருப்பினும், எந்த அளவிற்கு மொபைல் போன்கள் நம்மை காப்பாற்றுகிறதோ அதே அளவு - மலட்டுத் தன்மை, புற்றுநோய், இதய பாதிப்பு என நம்மை 'மெல்ல மெல்ல' கொன்று கொண்டும் இருக்கிறது என்பது தான் நிதர்சனம்.

01. மலட்டுத்தன்மை :
பாக்கெட்டில் வைக்கப்படும் மொபைல் போன் ஏற்படுத்தும் கதிர்வீச்சு மூலம் ஆண்களின் விந்து எண்ணிக்கை குறைகிறது என்பது உறுதி செய்யப்பட்டுள்ளது.

02. புற்றுநோய் :
ஸ்வீடன் நாட்டு ஆராய்ச்சியாளர்களின் சமீபத்திய ஆய்வின்படி அதிக மொபைல் போன் பயன்பாடு புற்றுநோய் மற்றும் மூளை கட்டியை உருவாக்கும் என்று அறிவித்துள்ளது.

03. தூக்க கோளாறுகள் :
மொபைல் போன் மீதான அதீத கவனம் உங்களை சரியாக உறங்க விடாது. சிறிய ரிங்டோன் அல்லது வைப்ரேஷன் கூட உங்களை எழுப்பி விடும்.

04. விபத்துகள் :
கையில் இருந்து மொபைல் போன் தவறி விழும் போது நாம் அனைத்தையுமே மறந்து விடுவோம். இந்த நிலையானது கீழே விழுவது தொடங்கி பெரிய விபத்து வரை ஏற்படுத்த வல்லது.

05. இதய பாதிப்புகள் :
மொபைல் போனில் இருந்து வெளிவரும் கதிர்வீச்சு ஆனது புற்று நோயை மட்டுமில்லை இருதய பதிப்புகளையும் ஏற்படுத்தும்.

06. காது கேளாமை :
மொபைல் போனில் இருந்து வெளிப்படும் மின்காந்த கதிர் வீச்சு காது கேட்கும் திறனை மெல்ல மெல்ல குறைத்துக் கொண்டே வரும்.

07. பார்வை கோளாறுகள் :
சிறிய ஸ்க்ரீன்கள் கொண்ட மொபைல் போன்கள் உங்கள் கண்களை குறுகிய நேரத்தில் பல முறை பரவலாக திறந்து மூட வைக்கிறது. இது பார்வை கோளாறுகளை ஏற்படுத்தும், முக்கியமாக இரவு நேரங்களில்.

08. தோல் ஒவ்வாமை :
மொபைல் போனில் உள்ள நிக்கில் (nickel), க்ரோமியம் (chromium) மற்றும் கோபால்ட் (cobalt) ஆகியவைகள் தோல் ஒவ்வாமையை (Skin allergies) ஏற்படுத்தும்.
09. தொற்று :
தெரியுமா உங்கள் கழிவறையை விட அழுக்கானது உங்கள் மொபைல் போன்கள். அவைகளால் மிக எளிதில் தொற்று ஏற்படுத்த முடியும்.

10. மன அழுத்தம் :
24 மணி நேரமும் மொபைல் போனை கையாள்பவர்களுக்கு மனஅழுத்தம் என்பதும் 24 மணி நேரமும் உடன் இருக்கும் தான்.

மேலும் படிக்க :

தமிழ் கிஸ்பாட் :
மேலும் இதுபோன்ற தொழில்நுட்ப செய்திகளை உடனுக்குடன் பெற - தமிழ் கிஸ்பாட் ஃபேஸ்புக் பக்கம் மற்றும் தமிழ் கிஸ்பாட் வலைதளம்..!



 Click it and Unblock the Notifications
Click it and Unblock the Notifications





























-1763362932432.svg)